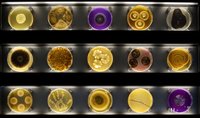
Amsterdamā atklāts pasaulē pirmais mikrobu muzejs

Kā jebkurā lielā pilsētā, arī Amsterdamā ir pasaulslaveni muzeji, un tūristi ir gatavi izdot kaudzi naudas, lai apskatītu mākslas darbus, kas tajos glabājas. Tomēr Amsterdama pazīstama arī kā pilsēta ar ļoti brīviem uzskatiem un netradicionālu domāšanu – piemēram, nekur citur nav tik neparasta ielu – kanālu sistēma kā šajā flāmu pilsētā, tādēļ nav nekāds pārsteigums, ka tur atrodami arī seksam un narkotikām veltīti muzeji, bet visvairāk šī pilsēta izceļoties ar visdažādākajām neparastu lietu kolekcijām, ko vairāku gadu garumā vākuši attiecīgo muzeju īpašnieki, raksta CNN.
Siera muzejs

Ikvienā sevi cienošā Latvijas pārtikas veikalā var atrast Holandes sieru, tādēļ likumsakarīgi, ka šim piena izstrādājumam ierādīta īpaša vieta - muzejā.
Perfektā pasaulē būtu uzņemta piektā filma par Indina Džounsa piedzīvojumiem, kurā tās varonis dotos meklēt sieru, kas noglabāts dziļi zem kāda tempļa drupām. Izceļot to no lamatām pārpilnās slēptuves, Indiana Džounss noteiktu: "Šī siera īstā vieta ir muzejā". Pēc tam viņam virsū sāktu velties milzīga Gaudas siera bumba.
Pasaule nav ideāla un šādas filmas nav, bet muzejs, kurā šis siers iederētos, noteikti ir Amsterdamas Siera muzejs – Holandes piena ražojumiem veltīta neliela divstāvu ēka iepretim Annas Frankas muzejam. Muzejā netrūkst visdažādāko vecumu, īpatnēju aromātu un interesantu leģendu apvītu sieru.
Neparasts muzeja eksponāts ir pasaulē dārgākais siera nazis, kas rotāts ar dimantiem un ir aptuveni 34 tūkstošus ASV dolāru jeb 28 tūkstošus eiro vērts.
Siera muzeja adrese ir 112 Prinsengracht Amsterdamā.
Kaķu muzejs

Visiem zināms, ka kaķu mīļi reizēm mēdz pārlieku pieķerties saviem mājdzīvniekiem, taču tas ir sīkums, salīdzinot ar holandieša Boba Meijera aizraušanos kas robežojas ar dievināšanu.
Kad bijušā baņķiera mīļotais mincis Dž. P. Morgans devās uz citiem medību laukiem, vīrietis nolēma pārvērst savu māju par svētnīcu mirušā mājdzīvnieka piemiņai.
Tā radās "De Kattenkabinet" – vairākas istabas 19.gadsimta beigās celtajā kanālmalas namā, kas pilnas ar gleznām un citiem priekšmetiem – viss par un ap kaķiem. Kolekcijā ietilpst arī kaķiem veltīti mākslas darbi, ko radījuši tādi mākslinieki kā Rembrants un Pikaso.
Meijers pats joprojām dzīvo ēkas augšstāvā kopā ar četriem kaķiem, tostarp, 19 gadus veco trīskrāsu kaķeni Liliju, kam ļoti patīk apmeklētāju pievērstā uzmanība. Neparasts muzeja eksponāts ir milzīga eļļas krāsu glezna, kurā attēlots burvis, kas nobur lielu, spocīgu kaķi.
Kaķu muzeja adrese ir 497 Herengracht Amsterdamā.
Holandiešu Bēru muzejs

Lai gan šis muzejs atrodas diezgan tālu no pilsētas centra, ceļu līdz tam ir vērts mērot. Par spīti drūmajai tematikai, Bēru muzejs jeb Tot Zover patiesībā nemaz nav biedējošs – tajā ļoti tiešā un saprotamā veidā attēloti dažādi holandiešu apbedīšanas rituāli un ar aizkapa dzīvi saistīti atribūti.
Muzejs atrodas kādreizējā kapsētas pārvaldnieka mājā netālu no ieejas kapsētā, bet tam blakus ir mājīga un gaiša kafejnīca, ko iecienījuši gan muzeja apmeklētāji, gan pilsētnieki.
Muzejā apskatāmas gan pēcnāves maskas, urnas un gleznas, gan dažādu tautu apbedīšanas rituālu piederumi un atribūti. Muzejā notiek arī izstādes, piemēram, pašlaik (līdz 4. janvārim) apskatāmas vairāk nekā 100 fotogrāfijas no Huiskamp Coachworks – holandiešu lielākās bēru servisa mašīnu ražotnes.
Neparasts muzeja eksponāts ir melni, četrstūraini deguni, kas radīti kā sērām atbilstoši klaunu sarkano degunu aizstājēji.
Holandes Bēru muzejs atrodas 124 Kruislaan Amsterdamā.
Somu un rokassomiņu muzejs

Vēl viena neparastu lietu kolekcija, kas ietilpināta milzīgā kanālmalas namā un neatstās vienaldzīgu nevienu dāmu, ir rokassomiņu muzejs. Iespaidīgais vēsturisku rokassomiņu un somu krājums apmeklētājiem atklājas pamazām, sākot ar niecīgiem metāla maciņiem, ko bija iecienījuši augstmaņi, kam seko mūsdienīgākas somas, piemēram, briežu vai cepuru formā, kā arī daudz un dažādi klasiski un avangardiski eksponāti. Muzejā aplūkojamas arī zīmola "Vlieger & Vandam" radītās somas ar naža un pistoles apveidiem no skandalozās "Guardian Angel" kolekcijas.
Neparasts muzeja eksponāts ir soma kā pārnēsājams telefons ar klausuli, ciparu ripu un garu vadu, ar ko to pieslēgt tīklam.
Somu un rokassomiņu muzeja adrese ir 573 Herengracht Amsterdamā.
Maksa Eives šaha muzejs

Protams, muzejs, kas veltīts vienai no pasaules senākajām spēlēm – šaham, pats par sevi nav nekas neparasts, taču šis muzejs ir atšķirīgs, jo veltīts vienam konkrētam šahistam.
Nelielajā muzejā, kas ierīkots kādreiz bēdīgi slavena cietuma pirmajā stāvā, attēlots Maksa Eives – Nīderlandes vienīgā pasaules čempiona šahā – dzīves gājums.
Šis muzejs ir sirsnīgs veltījums 1981. gadā mirušā Eives piemiņai, un, iespējams, ieinteresēs tikai šaha entuziastus, jo apmeklētājiem ir iespēja ielūkoties arī citās šīs ēkas telpās.
Ārpus ēkas atrodas liels šaha laukums, kur var vērot sacenšamies apdāvinātus jauniešus un profesionālus šahistus. Neparasts muzeja eksponāts ir šaha "slavas siena", kur iekļauti tādi lielmeistari kā Bobijs Fišers un Boriss Spaskis. Protams, tur ir arī slavenais rīdzinieks Mihails Tāls, kas ar holandieti Maksu Eivi tikās spēlē 1961. gadā.
Ieeja muzejā ir bez maksas.
Šaha muzejs atrodas Max Euwe Plein 30A Amsterdamā.
Nacionālais Briļļu muzejs

Šis ir muzejs tiem, kam patīk piemērīt citu cilvēku brilles – tātad, patiesībā, mums visiem. Tas atrodas vēsturiskā 19. gadsimta optiķa darbnīcā, kas gandrīz nemaz nav mainījusies kopš pirmie tās apmeklētāji, miedzot acis, ielūkojās pa tās logiem, un ir dāvājusi cilvēkiem labāku redzi jau 700 gadu garumā.
Kad muzeja briļļu kolekcija, sākot no senlaicīgiem, pūcēm līdzīgiem degunkniebjiem līdz masīvākām acenēm, kādas valkāja Badijs Hollijs un Elviss Kostello, ir aplūkota, var apmeklēt veikalu un iegādāties kādas acenes arī sev.
Neparasts muzeja eksponāts ir karnevāla maskas ar iestrādātām briļļu lēcām – tiem, kas grib atpazīt citus, paši paliekot neatpazīti.
Briļļu muzejs atrodas 7 Gasthuismolensteeg Amsterdamā.
Pīpju muzejs

Šķiet saprotami, ka pilsētā, kurā vesela nozare ir veltīta zināmu vielu smēķēšanai, ir muzejs pīpēm. Šis nav viens no Nīderlandei raksturīgajiem tabakas un citu smēķējamu vielu veikaliem - muzejā aplūkojami īsti, vēsturiski eksponāti, no kuriem daži ir pat no 2500 gadu senas pagātnes, kad darvas dūmu ieelpošana tika uzskatīta par veselīgu.
Burvīgajā 17. gadsimta kanālmalas ēkā atvēlēta vieta pīpēm, kas paredzētas, lai smēķētu ko stiprāku, kā arī elegantiem eiropiešu smēķēsanas rīkiem, kas radīti ikdienas lietošanai.
Neparasts muzeja eksponāts ir pīpe, kas darināta no krabja spīlēm.
Pīpju muzejs atrodas 488 Prinsengracht Amsterdamā.
Kā nokļūt Amsterdamā un atrast muzejus?

No Rīgas uz Amsterdamas Šipholas (Schiphol) lidostu var aizlidot ar aviokompānijas airBaltic tiešo reisu. Tāpat vienkārši turp nokļūt ar ungāru kompāniju Wizzair, lidojot līdz Eidhovenai un tālāk braucot ar vilcienu.
No Rīgas uz Amsterdamu regulāri kursē arī starpvalstu autobusi, kā arī, ieplānojot garāku atvaļinājumu, turp var doties ar personīgo transportu.
Pilsētā ir ērta sabiedriskā transporta sistēma – autobusi un tramvaji, kā arī kuģīši. Tomēr pašu vietējo iedzīvotāju iecienītākais transporta līdzeklis ir velosipēdi.
Vairāk par Amsterdamas apskati un objektiem lasiet šajā Turismagids.lv rakstā.
Visi septiņi aprakstītie Amsterdamas muzeji atzīmēti kartē.
View Amsterdamas muzeji in a full screen map